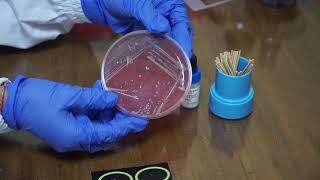

- VIDEO LECTURE: Uji Triaksial

Video lecture mengenai Uji Triaksial (mata kuliah Mekanika Tanah (SIL 211)) oleh Departemen Teknik Sipil dan Lingkungan (SIL), Fakultas Teknologi Pertanian ... Watch Now
Watch Now
Jumat, 20 September 2019
Uji Triaksial Mekanika Tanah
Uji Proporsi Satu Sampel
- Statistika Industri - Uji Hipotesis: Proporsi 1 Populasi #BATIN

Uji Proporsi 1 Populasi merupakan pengujian suatu hipotesis untuk menarik kesimpulan mengenai kebenaran hipotesis tersebut. Mau tau lebih lengkapnya ... Watch Now
Watch Now
Uji Praklinik Adalah
- Gedung Lab Hewan Percobaan di Jepang - Uji Pra Klinik

Gedung Hewan Percobaan di Jepang - Edisi Edukasi laboratorium hewan untuk uji pra klinik yang patut dicontoh. Video ini bersifat pribadi, jika ingin menonton ... Watch Now
Watch Now
Uji Pemadatan Tanah Di Laboratorium
- Pengujian Tanah Kepadatan Standar Laboratorium/Laboratory Soil Compaction Test

Video pengujian kepadatan standar laboratorium ini dibuat untuk membantu menjelaskan cara melakukan pengujian, baik kepada mahasiswa, praktisi maupun ... Watch Now
Watch Now
Uji Outlier Menurut Para Ahli
- Uji Normalitas Kolmogorov Smirnov dengan SPSS Full Edisi

Panduan cara melakukan Uji Normalitas Kolmogorov Smirnov pada nilai residual untuk model regresi linear dengan program SPSS sangat lengkap. Watch Now
Watch Now
Uji Normalitas Tidak Normal
- Cara Mudah Mengatasi Data Tidak Normal dengan Transformasi di SPSS

Cara Mudah Mengatasi Data Tidak Normal dengan Transformasi di SPSS. Watch Now
Watch Now
Uji Molisch Pada Karbohidrat
- UJI KARBOHIDRAT: UJI MOLISCH DAN UJI BENEDICT

UJI KARBOHIDRAT: UJI MOLISCH DAN UJI BENEDICT. Watch Now
Watch Now
Uji Mann Whitney Sampel Besar
- Uji Dua sampel BERPASANGAN (After - Before)

Cara mengolah Uji Beda rata-rata dua sampel berpasangan dengan R package R-Commander (RDMCR). Watch Now
Watch Now
Uji Konsistensi Data Hujan
- Uji Homogenitas Levene Statistics dengan SPSS Sangat Lengkap

Video cara uji homogenitas levene statistics menggunakan program SPSS untuk statistik parametrik dengan interpretasi lengkap. Untuk latihan Praktik Uji ... Watch Now
Watch Now
Uji Konsistensi Data Curah Hujan
- Uji Homogenitas Levene Statistics dengan SPSS Sangat Lengkap

Video cara uji homogenitas levene statistics menggunakan program SPSS untuk statistik parametrik dengan interpretasi lengkap. Untuk latihan Praktik Uji ... Watch Now
Watch Now
Uji Keseragaman Data Adalah
- Perhitungan Uji Homogenitas

Perhitungan untuk menentukan apakah suatu sampel homogen atau tidak, dengan menggunakan nilai F hitung (MSB/MSW) yang dibandingkan dengan nilai F ... Watch Now
Watch Now
Uji Kecukupan Data Adalah
- Melakukan Perhitungan Manual Uji Validitas dengan MS Excel

Vidio INi. Watch Now
Watch Now
Uji Kecocokan Model (goodness Of Fit)
- Judi Alhilman goodness of fit

menjelaskan mengenai uji chi square untuk uji kecocokan secara cepat. Watch Now
Watch Now
Uji Kecocokan Model (goodness Of Fit) Pdf
- How to Use SPSS: Chi Square Test for Goodness of Fit

Compare the proportion of categorical outcomes with hypothesized values. Watch Now
Watch Now
Uji Iodium Pada Karbohidrat
- UJI KARBOHIDRAT menggunakan METODE IODINE / IODIUM

Nama : Dewi puspita sari Nim : 1701014. Akademi Farmasi Yannas Husada Bangkalan Uji karbohidrat menggunakan metode iodine adalah cara sederhana ... Watch Now
Watch Now
Uji Iodium Pada Amilum
- uji amilum

Video ini berisi percobaan untuk menguji keberadaan amilum pada daun -------------------------------------------------------------------------------- Tim Prodi Pendidikan IPA, ... Watch Now
Watch Now
Uji Iodin Pada Karbohidrat
- UJI KARBOHIDRAT menggunakan METODE IODINE / IODIUM

Nama : Dewi puspita sari Nim : 1701014. Akademi Farmasi Yannas Husada Bangkalan Uji karbohidrat menggunakan metode iodine adalah cara sederhana ... Watch Now
Watch Now
Rumus Uji Konsistensi Curah Hujan
- Perhitungan Uji Homogenitas

Perhitungan untuk menentukan apakah suatu sampel homogen atau tidak, dengan menggunakan nilai F hitung (MSB/MSW) yang dibandingkan dengan nilai F ... Watch Now
Watch Now
Uji Iodin Adalah
- Ujian Iodin

Ujian Iodin adalah digunakan bagi menguji kehadiran kanji dalam sampel makanan. Titiskan dengan iodin, maka anda akan mendapat larutan biru kehitaman. Watch Now
Watch Now
- uji impact(impact Test)

Uji impak adalah pengujian dengan menggunakan pembebanan yang cepat (rapid loading). uji Impact merupakan Metode Merusak (Detructive Test) tujuan di ... Watch Now
Watch Now
Uji Hedonik Adalah
- Uji Hedonik

Permintaan siswa untk dibuatkan video pembelajaran uji organoleptik menggunakan uji hedonik. Berikut ini videonya. Semoga dapat membantu teman-teman ... Watch Now
Watch Now
Langganan:
Komentar (Atom)